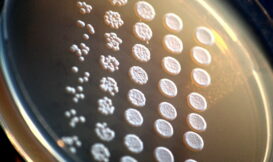

最新文章
菜配囧
・2015/01/29
Google Lunar XPRIZE登月競賽要求私人太空船安全登陸月球表面,行進至少500公尺,並將高畫質視訊和影像傳回地球。鼓勵全球各地的工程師和企業家,開發低成本的機器人太空探索方式,這些成就代表這次重返月球之旅的關鍵時刻。
Gilver
・2015/01/29
在森林、在海洋、在草原沙漠裡,存在與人類社會迥然不同的野生動物生態圈。人類亟欲窺伺動物們的日常生活,駐足於動物園以及電視播放的動物特輯前,卻難得有機會能夠真正一探究竟。實際與野生動物們相處是什麼感覺?有什麼樣的撇步?如果短期內無法親身參與,那麼就來本次的M.I.C.,讓長期與野生動物相處的生態攝影導演許鴻龍,以及曾在南非擔任獸醫志工的胡雁宜,一同分享與動物親密接觸的每一瞬間!
葉綠舒
・2015/01/29
最近研究團隊發現,麵包酵母會形成群落,其實是來自於基因突變:一個稱為ACE2的轉錄因子失去功能後,便會使得麵包酵母形成群落,這可能是最終產生多細胞生物的一條可能的演化途徑。
張瑞棋
・2015/01/28
1986 年的今天,佛羅里達的甘迺迪太空中心的發射台上,挑戰者號太空梭已準備就緒。天氣晴朗,然空氣峭冷凜冽,現場已有約五百名記者與多架攝影機準備報導。這一次是挑戰者號太空梭第十次出任務,在眾人的期盼之中,挑戰者號終於在美東時間上午 11 點 38 分緩緩升空。不料,59 秒後太空梭右側的固態火箭推進器出現白煙,接著出現火苗,第 73 秒挑戰者號在眾人的驚呼聲中爆炸解體,七名太空人全部罹難。
林希陶
・2015/01/28
立法院近日三讀通過「兒童及少年福利與權益保障法部分條文修正案」,明訂兒少持續使用3C產品不得超過「合理時間」。身為家長與臨床心理師的雙重角色,當然相當關心此一議題。我們都知道 3C產品不要使用太久,但是時間上到底要如何拿捏,實際上是否有科學方面的佐證?或許可以參考美國小兒科醫學會對於3C產品與大眾媒體一連串的政策宣言。
蘇 上豪
・2015/01/28
立普妥的副作用可能致命?血管收縮素轉化酵素抑制劑可能引起乾咳?服用藥物固然有些副作用需要注意,但最忌患者自行決定吃那些藥、不吃那些藥,藥是服用藥物有任何不適,不只是看藥袋上條列的副作用,應該儘早使用醫院的藥師諮詢專線,或是撥空再到門診找醫師談一談,才不會讓治療大打折扣。